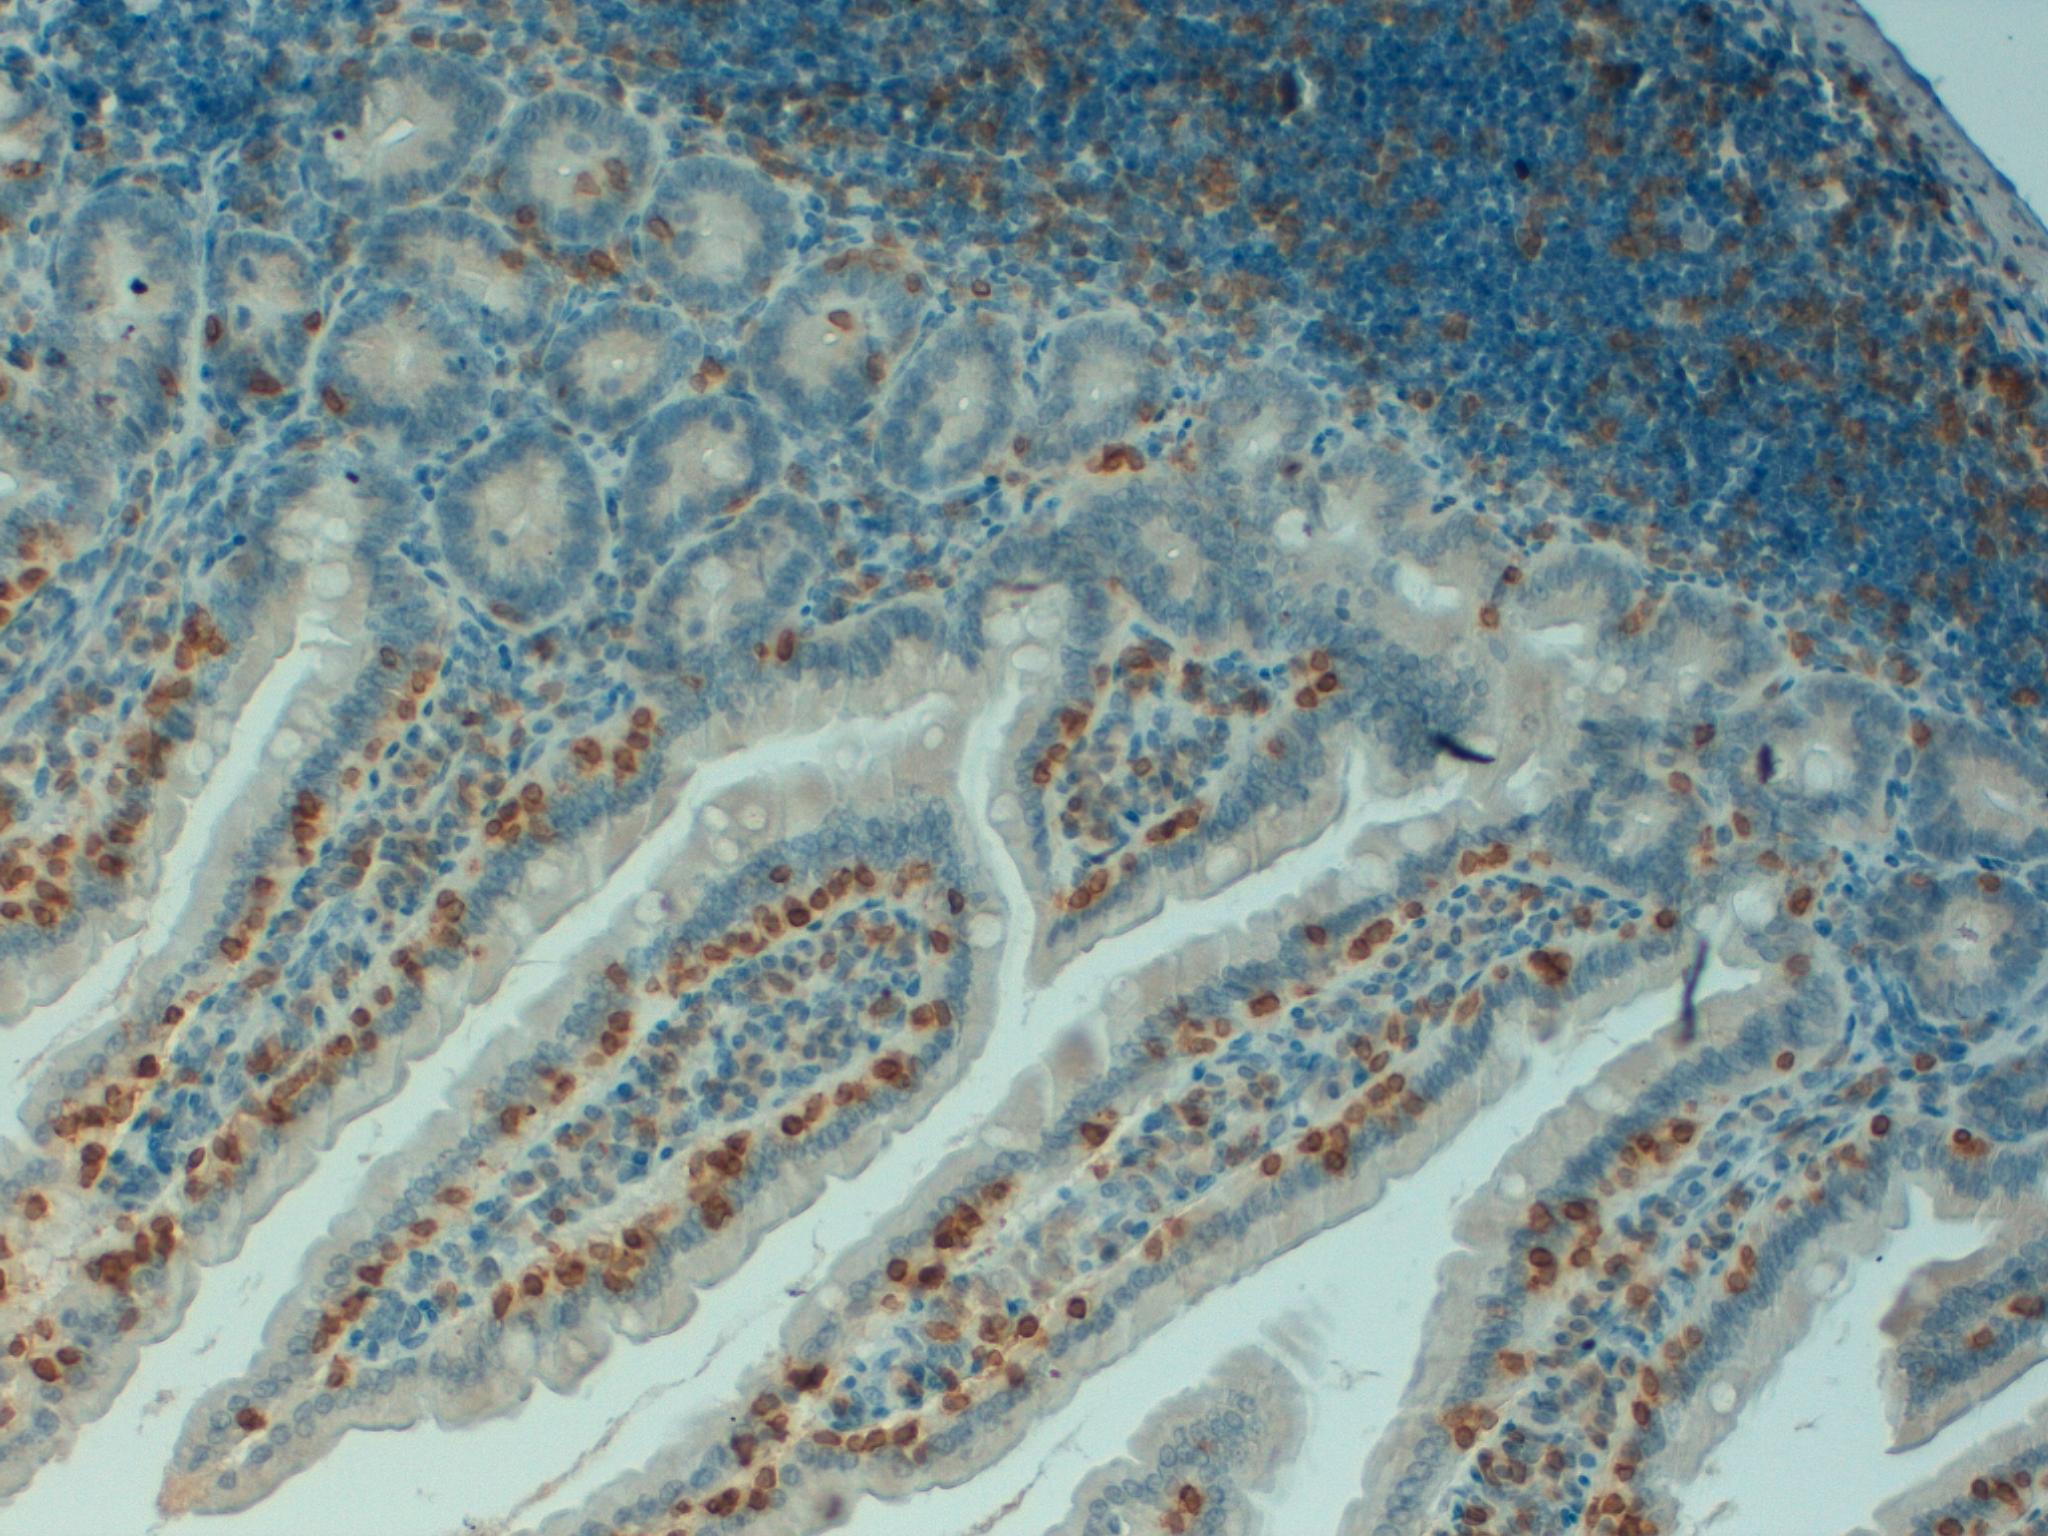
Mouse Colon 20x CD3
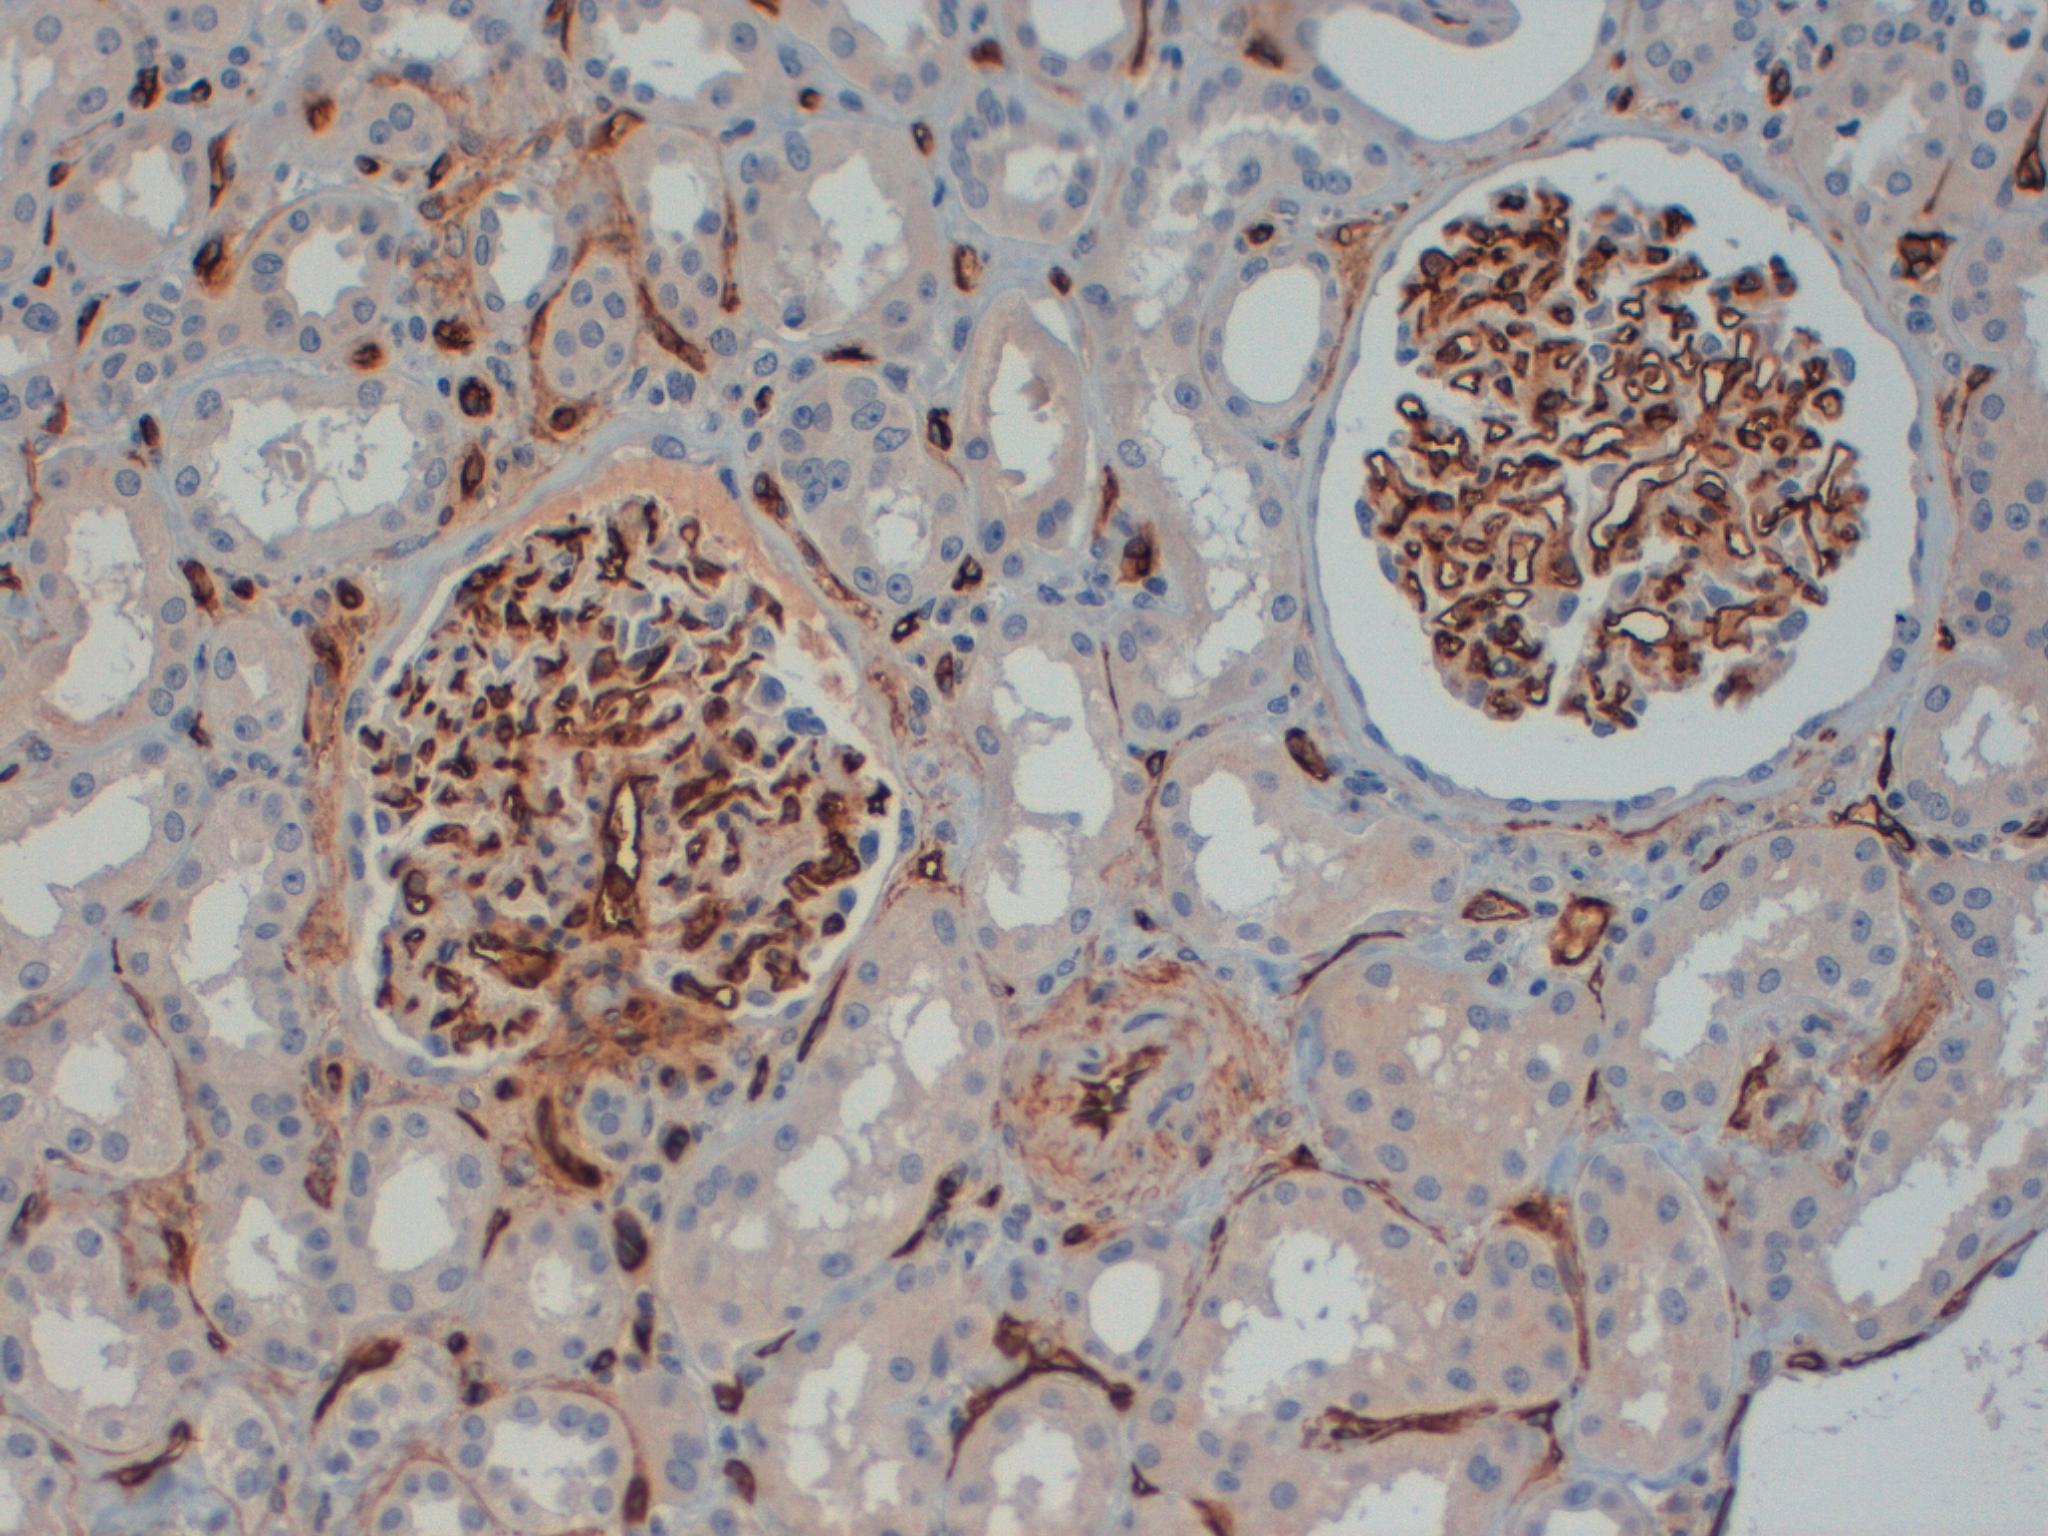
CD34 Kidney 40x
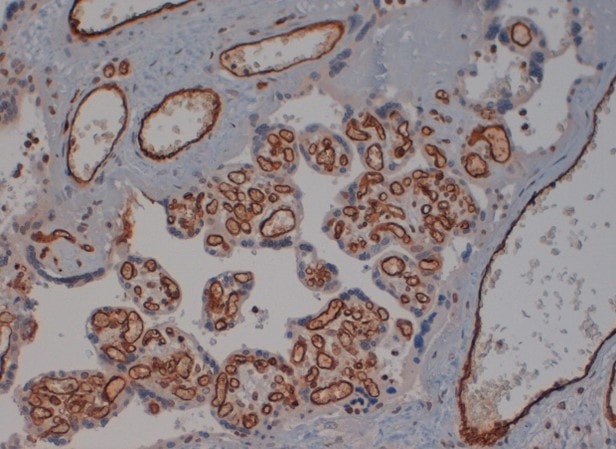
IHC Validation Service by Labospace

Histopathology & Antibody Validation
Histopathology & Antibody Validation
Our Pathology service is managed by our highly qualified team able to perform Histopathology and Histology testing on Human, Mouse or any other Species Specimens.
Our experts can provide specialized and personalized advice on project planning and development, from the positioning of the specimen during the embedding up to the full layout of the experiment.
Our full-service histology laboratories and hubs strategically positioned in Europe takes available both the infrastructure and the scientific expertise to readily meet the evolving needs of our customers.
Your research goals are time-sensitive, that’s why we have a Biobank of validated and approved tissues that will save you time and greatly reduce your costs.
Standard and proprietary validated protocols are ISO driven and approved and our commitment to quality is underlined by having all our services under ISO 9001:2015.
What to expect from our Pathology Service
• We fully manage your specimens, or you can have access to pathological samples ethically approved and fully validated from our biobank source
• Full technical and scientific support with tailored consultancy service to meet your experimental and research needs
• We accept fresh tissue, cells, paraffin-embedded tissue, unstained slides and any other type of tissue/samples, the following tests are available according to your needs
• We process, section, and stain specimens according to your specifications
• A full range of routine and special histological stains for paraffin and frozen tissue sections
• We use standardized staining protocols with careful reagent management to minimize artefacts, high background and false positives.
• Tissue repository available
• We have a large and growing panel of over 500 antibodies with fully optimized protocols for use on human, murine and other tissues
• High-quality results for your custom requirements
• Detailed Pathologist's Report (on request)
• Digital Slide Scanning and temporary storage
Our Pathology Services
Histology Services
H&E Staining
Special Staining
Additional Block
Reading and Reporting


I am a heading
Multiplex IHC Staining: Mouse Colon, Colorazione HE
Immunohistochemistry
Services
Setup of Primary Antibody for IHC
Single IHC & Multiplex IHC Staining
Image and Data Analysis by certified Pathologist (if requested)
Single IHC & Multiplex IHC Staining
Image and Data Analysis by certified Pathologist (if requested)


I am a heading
Multiplex IHC Staining: Human Lung CD68/cb-1 Single IHC Staining: Human Placenta, CD34

Nestin Nervous Xenograft 40X 
Nestin Nervous Xenograft 40X 
KI67 Mouse Lung 20X 
KI67 Mouse Liver 20X 
KI67 Mouse Intestine 20X 
KI67 Mouse Intestine 10X 
KI67 Mouse Colon 20X 
CD31 Mouse Liver 20X 
Mouse colon 40x lamda chains 
Mouse colon 40x CD138 
Mouse colon 40x F4 80 
Mouse colon 40x kappa chains 2 
Mouse Colon 40x CD138 
Mouse Colon 40x CD3 
Mouse Colon 40x GRI 
Mouse Colon 40x CD45 
Mouse Colon 40x CD45 
Mouse Colon 20x Lambda Chains 
Mouse Colon 20x Lambda Chains 
Mouse Colon 20x ki67 
Mouse Colon 20x Kappa Chains 
Mouse Colon 20x CD138 
Mouse Colon 20x CD3 
Mouse Colon 20x CD45 
Ki67 and Caspase 3 - Double Staining 20x 
Kappa Lambda Double Staining 20x 
Ki67 and Caspase 3 - Double Staining 10x 
Kappa Lambda Double Staining 10x 
CD34 Kidney 40x 
CD4 BOM 20x 
IHC Antibody Validation by Labospace 
IHC Validation Service by Labospace
Contact us about our Pathology and Histopathology Service
We’re here to discuss your needs and help you decide on the best protocol for your project.
We will aim to respond within two business days to arrange your free consultation.